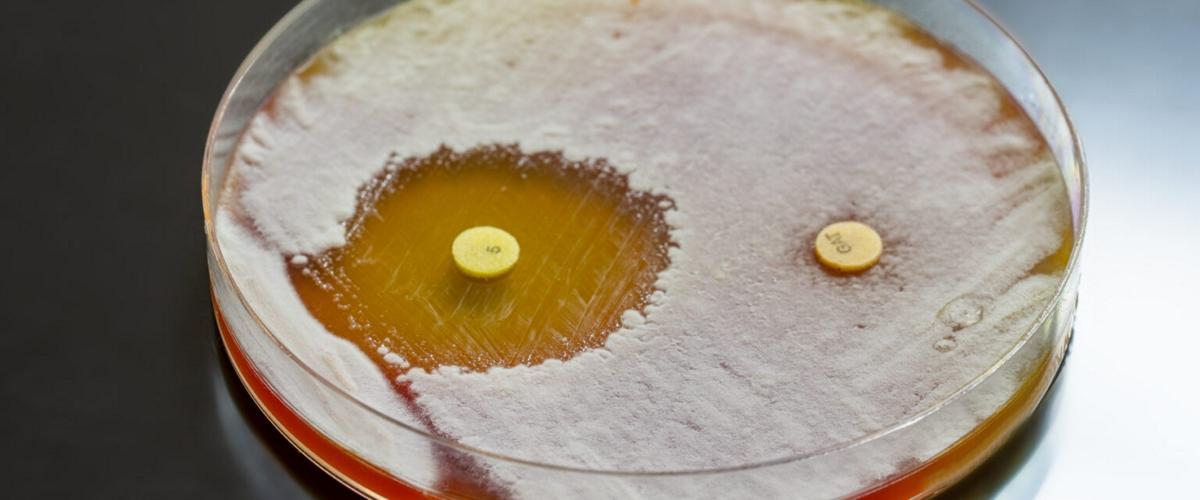
TODO:

Исследователи из Университета Дьюка представили результаты научной работы, в которой сообщается о существовании уровня «эгоистичности» бактерий в отношении их адаптации. Вывод основан на изучении механизма развития резистентности бактерий к пенициллину — бета-лактамному антибиотику.
Известно, что для разрушения этого класса лекарств бактерии используют специальный фермент. Многие ученые работают над созданием препаратов для подавления фермента, однако результаты экспериментов противоречивы и до сих пор исследователи не понимали причин.
«Теперь ясно, что причина проста. Если из-за генетических особенностей бактерия ведет себя эгоистично и не делится ферментом, то ее шансы на выживание велики, а если она запрограммирована делиться, то нет», — прокомментировал результаты экспериментов автор исследования Линчонг Джеймс Мериам.
Новое понимание механизмов формирования резистентности позволит создать целевые препараты для подавления эгоистичных бактерий, а также адаптировать существующую антибактериальную терапию против конкретных штаммов.
Сегодня проблема резистентности бактерий к антибиотикам стала глобальной и по уровню смертности опережает СПИД и малярию. В поисках решения ранее ученые разработали антибиотик, который в 100 млн раз затрудняет выработку резистентности. Это стало возможно благодаря одновременному разрушению двух клеточных мишеней.